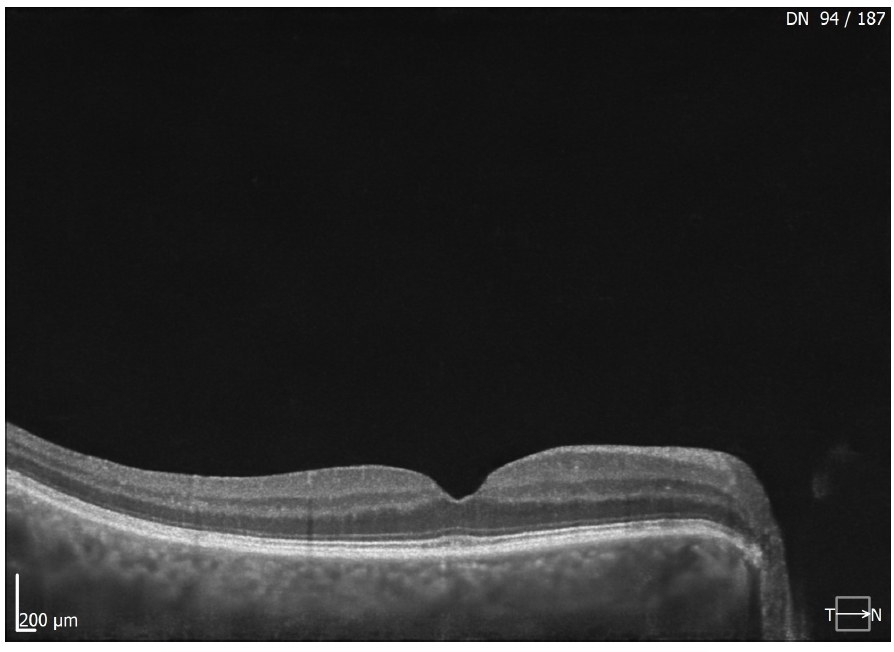

Specialista in Oftalmologia dal 2006, Dirigente Medico UOC Oftalmologia Ospedale G.B. Grassi Ostia – Roma.

Via Appia Nuova, 71 00183 Roma
Tel. 0670491941
Retinopatia Diabetica
Degenerazione Maculare Senile
Occlusioni Vascolari Retiniche
Malattie Rare (Retinite Pigmentosa, Malattia di Stargardt, Albinismo Oculocutaneo)
Glaucoma
Oftalmopatia Tiroidea (Orbitopatia di Graves)
Esami strumentali
SDOCT e Angio-OCT
OCT Segmento Anteriore e Cornea
Topografia Corneale e Pachimetria Corneale OCT
Campo Visivo